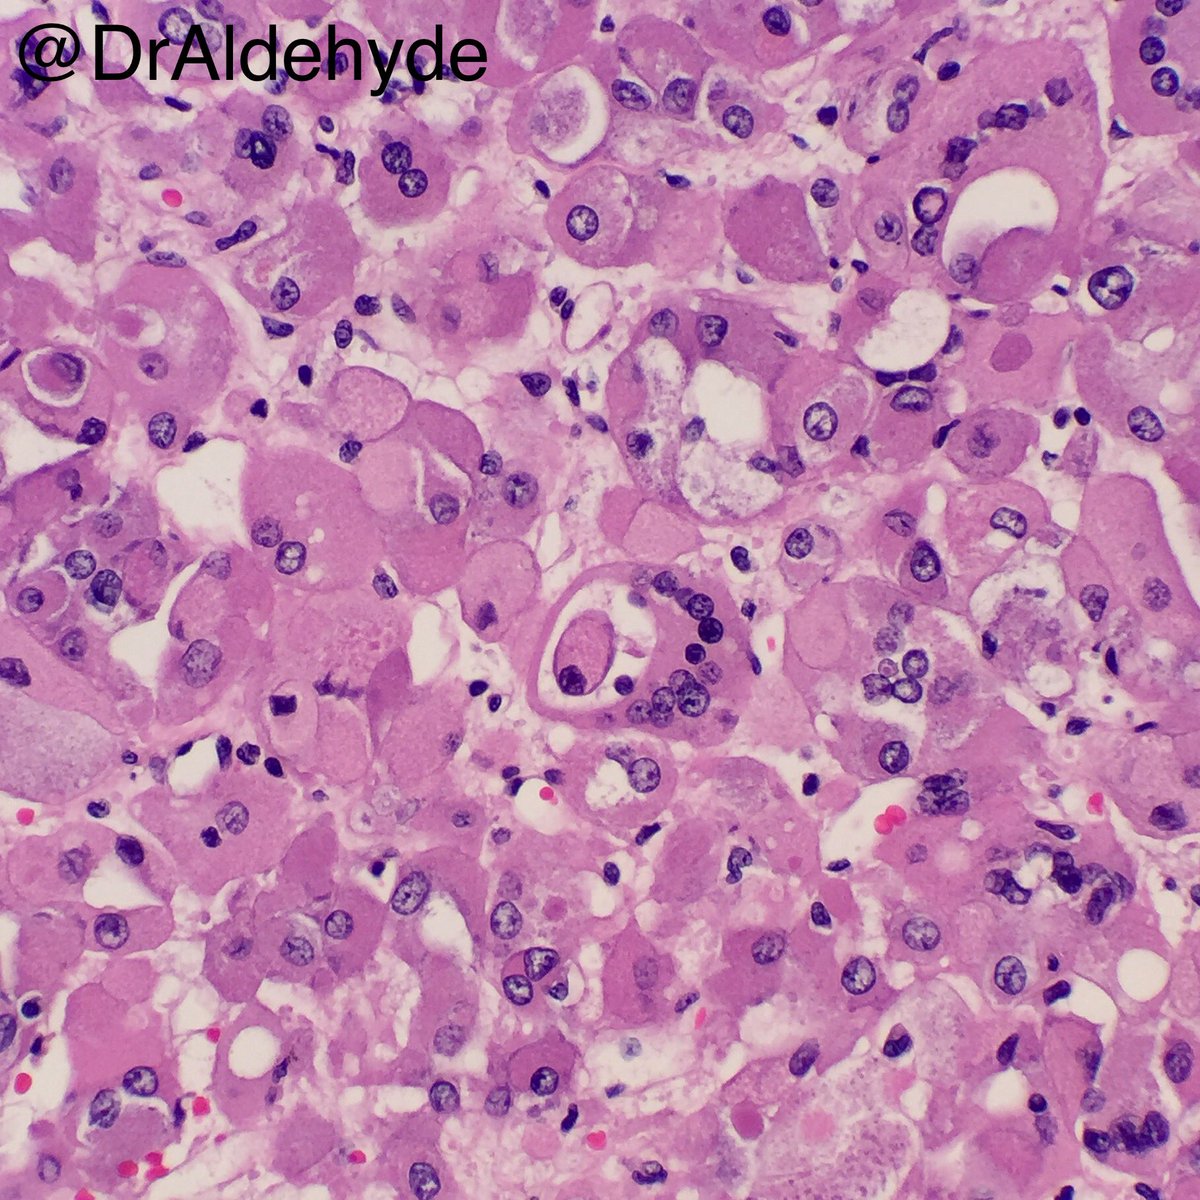
Woo Cheal Cho, MD tweet media

Steven Long, MD retweetledi
Steven Long, MD
2.1K posts

Steven Long, MD
@SteveLongMD
UCSF Pathology. Cytology, FNA, USFNA, ENT SurgPath Cyto-Heme Inter-institutional Collaborative (CHIC). SF General. Clinical Professor. Fna for profiling
San Francisco, CA Katılım Mart 2016
2.5K Takip Edilen3.9K Takipçiler
Steven Long, MD retweetledi
Steven Long, MD retweetledi

Gearing up to spend my Saturday immersed in a wonderful case-based course at @UCSFPath. Excited to learn from such an incredible program organized by Dr. Rabban @joerabban
#GynPath

English

👀 Coming soon! UCSF Pathology
Interactive Microscopy Course - GYN and Breast Biopsies. 75 digital biopsies presented/ reviewed. Fantastic learning opportunity and update! May 23rd. Come join us in SF 🙌 Sign-up Now. #Pathtwitter #GynPath #BreastPath #DigitalPath

English

UCSF Pathology Live Interactive Microscopy Course on Breast and Gyn Biopsies. May 23rd. 75 digital cases will be presented. Great Pathology Learning Opportunity 👀 #PathTwitter

English
Steven Long, MD retweetledi

New option for live-streaming our #gynpath #breastpath interactive digital slide-based course on May 23. Also FREE access for low-middle income country pathologists/trainees. Link to the digital slides will be sent for previewing in advance. Register: ucsf.cloud-cme.com/course/courseo…

English
Steven Long, MD retweetledi

New option for live-streaming our #gynpath #breastpath interactive digital slide-based course on May 23. Also FREE access for low-middle income country pathologists/trainees. Link to the digital slides will be sent for previewing in advance. Register: ucsf.cloud-cme.com/course/courseo…

English
Steven Long, MD retweetledi

#breastpath can be challenging...why not spend a day in 😎🌴🌞Palo Alto and come learn from experts in the field?
@SouthBayPath hosting 67th annual Spring Meeting, this year focused on breast pathology
⏬signup below!
eventbrite.com/e/67th-annual-…
English

Come join our all new Interactive Microscopy course in SF May 23rd.
It’s going to be Great 🙌 SF is on the Rise #PathTwiiter #GynPath #BreastPath 75 digital cases presented and reviewed.


English
Steven Long, MD retweetledi
Steven Long, MD retweetledi

Announcing a 1 day Interactive Microscopy course on #GYNpath and #breastpath biopsies in San Francisco, CA, May 23, 2026. Digital slides of 75 cases on practical issues in classification/reporting. Designed for audience interaction. Cases available to preview online in advance.

English
Steven Long, MD retweetledi

Free CSP Webinar Tomorrow:
Systemic Mastocytosis: Overview of Disease and Diagnosis for Pathologists
🗓 March 19, 2026
⏰ 3:30 PM PDT
💻 Virtual (Zoom)
Presented on behalf of Blueprint Medicines by Alejandro Gru, MD (Columbia University), board-certified in anatomic pathology, dermatopathology, and hematopathology.
Register here: ow.ly/Hq3050Yw7qu

English
Steven Long, MD retweetledi

Daniel Jeremiah has released his Mock Draft 3.0, with a couple really interesting picks in the Top 5: nfl.com/news/daniel-je…
nfl.com/news/daniel-je…
English
Steven Long, MD retweetledi
Steven Long, MD retweetledi

New! Interactive microscopy course in S.F. Registration now Open, 5/23/26
#PathTwitter #GynPath #BreastPath
Breast and Gyn digital biopsies

English
Steven Long, MD retweetledi

Interested in an immersive 1 day #gynpath and #breastpath interactive microscopy CME course? Come study 75 digital slide biopsy cases, available to preview online,and discuss directly/ask questions with the speakers. May 23 at UCSF, San Francisco, CA. Special rate for trainees

English
Steven Long, MD retweetledi

@DrAldehyde IMO most trainees coming out now with 1 or less fellowships are inadequately trained
I’m👀 high turnover from these folks leaving first job they take, & big🔬mistakes on rereviews
I’d urge trainees to soak up🧠now as much as possible during residency - fellowships included
English

The job market is at a record high and very strong, but there are too many fellowship positions nationwide, and new ones are constantly being created in #pathology. Trainees can easily find jobs without completing a fellowship, so how are programs going to fill their spots? 🫠🔬
English













